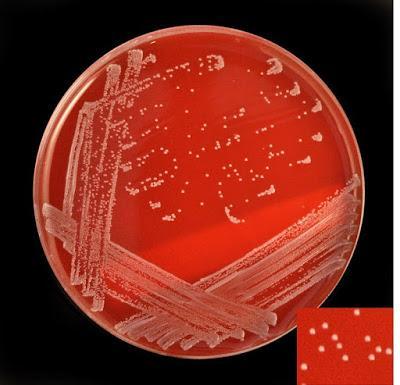
farmaceuticainmavinue

La difteria ¿Qué es?
Ya se conocía esta enfermedad en el siglo V antes de Cristo, así que como ves, el bacilo causante de la difteria hace muchos ,muchos siglos que convive con nosotros.Fue en el año 1921 cuando Behring obtuvo el suero antidiftérico y contribuyó así a la prevención de la enfermedad mediante la vacunación.
A partir de ahí se modificó sustancialmente la epidemiología de la enfermedad, de modo que por ejemplo en España hace más de 30 años que no se daba un sólo caso de difteria.
Es una enfermedad infecciosa de declaración obligatoria cuyo agente causante es una bacteria, bacilo Gram + y que solo es capaz de encontrarse en el Hombre.
Produce una potente y letal exotoxina.
¿Cómo se contagia la difteria?
Esta enfermedad se transmite a través de las pequeñas gotitas respiratorias que emitimos al hablar,al toser,al estornudar, desde el paciente enfermo o el individuo portador (no presenta síntomas).También puede ocurrir por contacto con las secreciones respiratorias o contacto con el exudado de las lesiones cutáneas infectadas.
Tiene un periodo de incubación de entre 2 y 5 días.
Signos y síntomas de la difteria
El bacilo de la difteria o Corynebacterium diptheriae penetra por las vías respiratorias e invade las mucosas de las amigdalas y de la faringe.
Se observará según la localización de la bacteria,síntomas de laringitis,faringitis y difteria cutánea.
En la difteria faringo-amigdalar, hay fiebre alta,disfagia,voz gangosa,ganglios inflamados. Después se forman una membranas típicas blanco-nacaradas en las amígdalas y que sangran con facilidad.
En la difteria faringea-nasal, se da rinorrea sanguinolenta y se ven estas membranas en el tabique nasal.
El mayor problema son las complicaciones , ya que las toxinas pueden afectar al corazón,al riñón y al cerebro.

La vacuna frente a la difteria
En España la vacunación frente a difteria se introdujo en 1945. Y desde 1965 se vacuna de forma sistemática a la población infantil con una vacuna combinada con antipertussis , toxoide tetánico y frente al bacilo corynebacterium diptheriae en la vacuna llamada DTP.Esta vacuna, por lo tanto, es una vacuna trivalente, DTP (iniciales de Difteria,Tétanos y Pertussi) generalmente.
Con cuatro dosis de DTP se adquieren anticuerpos protectores. Esta inmunidad persiste durante 5 años, y disminuye progresivamente hacia el décimo año,por lo que es necesaria una dosis de refuerzo cada 10 años.
Ni la vacunación, ni la enfermedad confiere inmunidad permanente.
Comienza la vacunación a partir de los 2-3 meses de vida, según el calendario vacunal que ofrece cada comunidad autónoma.
Si queréis saber como va el calendario de vacunación infantil según la Comunidad Autónoma en la que vives,lo puedes hacer aquí http://www.portalfarma.com/ciudadanos/saludpublica/vacunacion/calendario-vacunacion/Paginas/vacunacion.aspx

Calendario vacunacion infantil en Aragón 2014
Se recomienda en los adultos no vacunados en la infancia o si han transcurrido más de 10 años desde la última dosis. En mujeres en edad fértil no vacunadas y en embarazadas se recomienda retrasar al segundo trimestre.
Sólo recordar que el control de las enfermedades infecto-contagiosas mediante la vacunación infantil supone uno de los mayores adelantos médicos del siglo pasado.
Si te has gustado,puedes compartirlo.
Si tienes alguna duda,utiliza el formulario de contacto.
¡Hasta pronto!

